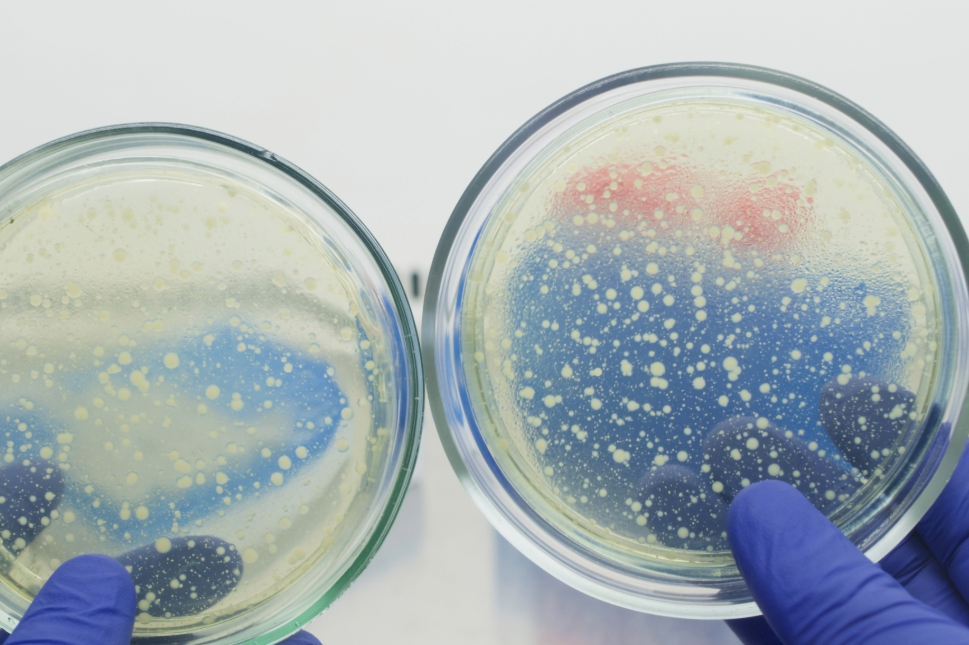
bakterier i petriskål

Fjern røyklukt etter sigaretter i Oslo, Drammen, Bærum, Asker og Lillestrøm
Røyklukt setter seg i alt – vegger, tak, ventilasjon og gulv. Med Decon-X sin dokumenterte metode fjernes lukten på 6 timer, uten ozon og uten å skade inventar.
Derfor sitter røyklukten igjen – selv etter vask og maling
Nikotin og tjærestoffer fra sigarettrøyk trenger inn i porøse materialer som gips, treverk og fuger.
Selv etter vask og maling slipper de ut igjen når rommet varmes opp – spesielt i eldre boliger i Oslo, Drammen og Bærum.
- 🧪 Nikotinfilm legger seg som belegg
- 🧱 Trenger dypt inn i materialer
- 🔁 Frigjøres igjen ved varme

6-timers profesjonell gassing som når alle flater
💡 Viktig: Riktig forarbeid gir varig resultat. Fjern tekstiler, vask grundig og varm opp før vi kommer.
Ikke mal før behandling!
Å male over røykskadede vegger forsegler lukten – den vil lekke ut igjen når overflaten varmes opp.
🎨 Vent med maling til etter Decon-X-behandlingen er fullført.
Vitenskapelig dokumentert trygghet
|
Metode |
Effekt på lukt |
Helse / miljø |
Resultat |
|
Maling/vask |
Maskerer midlertidig |
Trygt, men ineffektivt |
Lukt kommer tilbake |
|
Ozonmaskin |
Ustabil og risikabel |
Potensiell helseskade |
Ofte kortvarig effekt |
|
Decon-X gassing |
Fjerner molekyler i dybden |
Trygg og dokumentert (NTNU) |
Varig frisk luft |
Les mer om EN17272
Vi hjelper deg der du bor
Decon-X tilbyr rask befaring og behandling i:
- Oslo: Borettslag og utleieboliger
- Asker & Bærum: Eneboliger og rekkehus
- Drammen: Eldre bygg og leiligheter
- Lillestrøm: Boliger med røykskade etter røyking eller brann
Uansett type bolig, hjelper vi deg med å gjenvinne et trygt og sunt inneklima.
Kontakt oss for gratis befaring i ditt område
Pust lett igjen! Vi hjelper deg å få kontroll.
Ikke la røyklukt ødelegge inntrykket av boligen eller verdien på eiendommen.
Vi tilbyr:
- Gratis førstesamtale
- Rask behandling (6 timer)
- Tiltaksplan med anbefalte løsninger
➡️ Bestill gratis befaring i Oslo, Drammen, Bærum, Asker eller Lillestrøm
Bestill en videobefaring med våre rådgivere 🤝
Under videobefaringen går vi gjennom problemet. Kartlegger områder som må behandles. Til slutt lager vi et tilbud på utbedring. Variget ca 15 min.
Videobefaring
Kartlegging. Tilbud. Gjennomføring. Dokumentasjon.